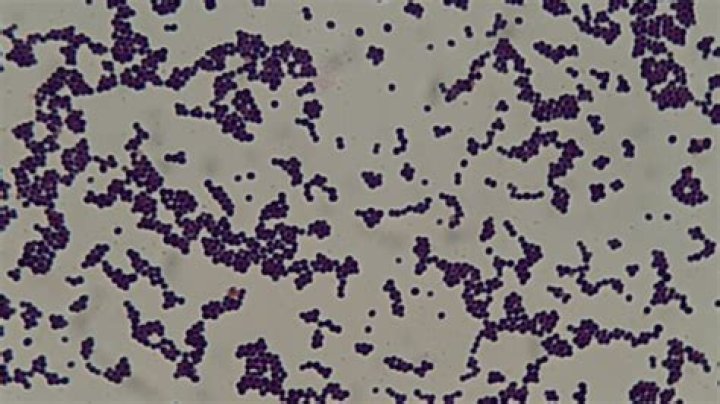
Cover

Staphylococcus epidermidis is a Gram-positive bacterium, and one of over 40 species belonging to the genus Staphylococcus.
Is E coli positive for oxidase test?
Microorganisms are oxidase negative if the color does not change. FIG. 4. This is a mixed culture of oxidase-negative Escherichia coli and oxidase-positive Vibrio cholerae showing how the direct oxidase test differentiates between the two organisms.
Is there a blood test for Staphylococcus?
Blood Test A test can also be used to determine whether you’re infected with methicillin-resistant Staphylococcus aureus (MRSA), a type of staph that’s resistant to common antibiotics.
Can Staphylococcus aureus be cured?
Many common skin infections caused by S. aureus will heal without medical treatment. However, some skin infections will require incision and drainage of the infected site and some infections may require antibiotics.
What is the biochemical test for Staphylococcus aureus?
Fermentation of Arabinose Negative (-ve) Cellobiose Negative (-ve) DNase Positive (+ve) Fructose Positive (+ve) Galactose Positive (+ve)
What does indole production test mean for Staphylococcus aureus?
After mixing, the bubble was seeming to appear. It means that gram-positive cocci are staphylococcus. Indole production test determines the capability of specific bacteria to decay amino acid to indole which gathers in the medium. Indole is produced by reductive deamination from tryptophan through indole pyruvic acid.
What happens if your staph test is positive?
Even if your test is positive for Staph, it does not mean you have an infection and your surgery will not be cancelled or delayed. A positive test means that prior to your surgery you will need to use a nasal ointment and bathe or shower with a special soap.
How to screen for Staphylococcus aureus before surgery?
Place a small amount of ointment on the tip of your finger or on a Q-tip and put on the inside front part of each nostril. Infection Control & Epidemiology Screening for Staphylococcus aureus before Your Surgery – 2 –
After mixing, the bubble was seeming to appear. It means that gram-positive cocci are staphylococcus. Indole production test determines the capability of specific bacteria to decay amino acid to indole which gathers in the medium. Indole is produced by reductive deamination from tryptophan through indole pyruvic acid.
What happens to agar plate after Staphylococcus aureus?
After incubating for 48 hours, the agar plate turned yellow on one side and stayed red on the other. This is an indication of a positive test. Therefore, this ensures that Unknown “A” is indeed Staphylococcus aureus.
What does Staphylococcus aureus look like on a TSA plate?
This shape is known as cocci. When grown on a TSA plate, Staphylococcus aureus appears to be yellow to opaque in color. S. aureus is known as one of the most resistant bacterium to multiple antibiotics and considered the most pathogenic.
Staphylococcus epidermidis is a Gram-positive bacterium, and one of over 40 species belonging to the genus Staphylococcus. It is part of the normal human flora, typically the skin flora, and less commonly the mucosal flora. It is a facultative anaerobic bacteria.
What tests are used to identify Staphylococcus aureus?
Coagulase testing is the single most reliable method for identifying Staphylococcus aureus [9]. Coagulase production can be detected using either the slide coagulase test (SCT) or the tube coagulase test (TCT).
Is Staphylococcus lactose fermenter?
aureus liquefy gelatin and showed positive results[16]. Our study reveals that all isolated S. aureus strains changes the colour of media from yellow to red, indicating positive reactivity in urea hydrolysis. In this study, all isolated strains showed a positive result in lactose fermentation test.
Is Staphylococcus aureus positive for starch hydrolysis?
aureus isolates showed positive results in gelatin, urea and galactose hydrolysis test, 50% isolates were positive in starch hydrolysis test, 35% in protein hydrolysis test, 100% isolates in lactose fermenting test, but no isolate was positive in sucrose fermenting test.
Is Staphylococcus catalase positive or negative?
Staphylococcus aureus is a gram positive, catalase and coagulase positive coccus and by far the most important pathogen among the staphylococci. It produces enzymes such as catalase which are considered to be virulence determinants.
Is Staphylococcus aureus gelatinase positive?
This test is helpful in identifying and differentiating species of Serratia, Proteus, Bacillus, Clostridium, Pseudomonas and Flavobacterium. This test differentiates pathogenic Staphylococcus aureus which is gelatinase-positive from non-pathogenic epidermidis which is gelatinase negative.
How did I get Staphylococcus aureus?
S. aureus is spread by touching infected blood or body fluids, most often by contaminated hands.
Is E. coli gelatinase positive?
The Escherichia coli culture remained solidified indicating that gelatinase was not produced. The red color in the agar is due to the pigment produced by Serratia marcescens.
How do you detect Staphylococcus aureus in blood?
A number of rapid tests for identification of Staphylococcus aureus directly from blood cultures have been reported. An agar diffusion method for thermostable-endonuclease (TE) detection was found to be an accurate test, with a sensitivity of 96 to 100% and 100% specificity (1, 11).
How do you diagnose Staphylococcus aureus?
Coagulase testing is the single most reliable method for identifying Staphylococcus aureus[9]. Coagulase production can be detected using either the slide coagulase test (SCT) or the tube coagulase test (TCT).
What diseases can coagulase negative staphylococcus cause?
Coagulase-negative staphylococcal skin conditions
- Miliaria.
- Atopic dermatitis.
- Competing against pathogens.
- Surgical site infections.
- Bacteraemia.
- Intravascular device infection.
- Prosthetic vascular graft infections.
- Prosthetic valve endocarditis.
What bacteria are gelatinase positive?
Bacillus anthracis, B. cereus and several other members of the genus are gelatinase-positive, as are Clostridium tetani and perfringens.